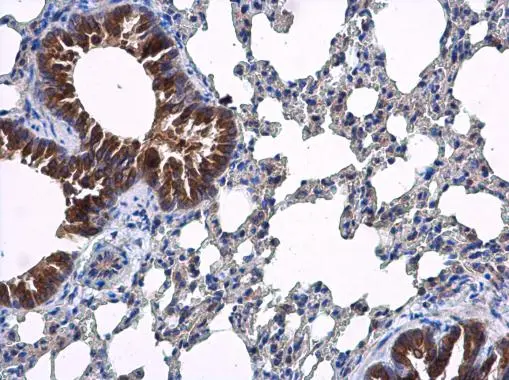
ARF5 antibody detects ARF5 protein at cytoplasm in respiratory epithelium of mouse lung by immunohistochemical analysis. Sample: Paraffin-embedded mouse lung. ARF5 antibody (GTX119329) diluted at 1:500.
 Antigen Retrieval: Citrate buffer, pH 6.0, 15 min

Sample (50 ug of whole cell lysate) A: mouse brain 12% SDS PAGE GTX119329 diluted at 1:1000
ARF5 antibody
GTX119329
ApplicationsWestern Blot, ImmunoHistoChemistry, ImmunoHistoChemistry Paraffin
Product group Antibodies
ReactivityHuman, Mouse
TargetARF5
Overview
- SupplierGeneTex
- Product NameARF5 antibody
- Delivery Days Customer9
- Application Supplier NoteWB: 1:500-1:3000. IHC-P: 1:100-1:1000. *Optimal dilutions/concentrations should be determined by the researcher.Not tested in other applications.
- ApplicationsWestern Blot, ImmunoHistoChemistry, ImmunoHistoChemistry Paraffin
- CertificationResearch Use Only
- ClonalityPolyclonal
- Concentration0.43 mg/ml
- ConjugateUnconjugated
- Gene ID381
- Target nameARF5
- Target descriptionARF GTPase 5
- Target synonymsADP-ribosylation factor 5, ADP ribosylation factor 5
- HostRabbit
- IsotypeIgG
- Protein IDP84085
- Protein NameADP-ribosylation factor 5
- Scientific DescriptionADP-ribosylation factor 5 (ARF5) is a member of the human ARF gene family. These genes encode small guanine nucleotide-binding proteins that stimulate the ADP-ribosyltransferase activity of cholera toxin and play a role in vesicular trafficking and as activators of phospholipase D. The gene products include 6 ARF proteins and 11 ARF-like proteins and constitute 1 family of the RAS superfamily. The ARF proteins are categorized as class I (ARF1, ARF2,and ARF3), class II (ARF4 and ARF5) and class III (ARF6). The members of each class share a common gene organization. The ARF5 gene spans approximately 3.2kb of genomic DNA and contains six exons and five introns. [provided by RefSeq]
- ReactivityHuman, Mouse
- Storage Instruction-20°C or -80°C,2°C to 8°C
- UNSPSC12352203